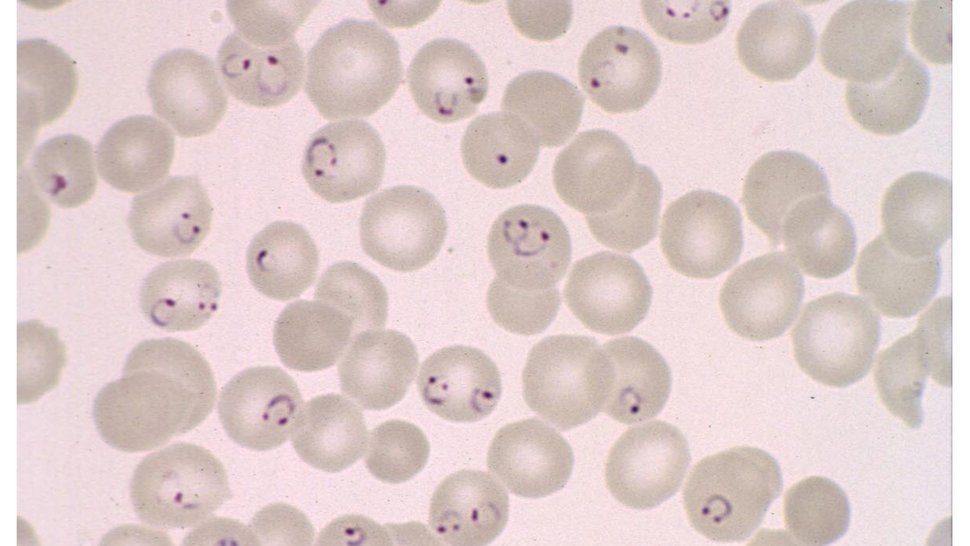
Eine mikroskopische Aufnahme zeigt rote Blutzellen, von denen einige mit Malariaparasiten befallen sind.

Autoimmunität schützt vor Malaria
Einblick in Wechselwirkung zwischen Infektionserkrankung und Autoimmunität
Malaria ist eine der bedeutendsten Infektionserkrankungen weltweit. Sie führt bei vielen Kindern zum Tod. Forschende des Bernhard-Nocht-Instituts für Tropenmedizin (BNITM) fanden in Zusammenarbeit mit Kooperationspartner:innen heraus, dass Autoimmunität den Menschen vor einer Malariaerkrankung schützt. Wie die Studie zeigt, hemmen Autoantikörper das Wachstum des Malariaparasiten und binden an Proteine, die wichtig für das Eindringen in rote Blutkörperchen sind. Die Studie wurde kürzlich in der Fachzeitschrift Immunity veröffentlicht.
Die Erkrankung Malaria gibt es schon seit mindestens Hunderttausend Jahren, sie hat den Menschen in seiner Evolution begleitet. Der einzellige Malariaparasit Plasmodium falciparum löst die schwere Erkrankungsform Malaria tropica aus. Im Jahr 2022 erkrankten schätzungsweise 250 Millionen Menschen an Malaria, der Großteil an der Malaria tropica; 600.000 von ihnen starben, die meisten davon Kinder.
Autoimmunität schützt vor Malaria
Autoimmunität bezeichnet eine Immunantwort, die auf körpereigene Strukturen gerichtet ist und zu Autoimmunerkrankungen wie Rheuma führen kann – Autoantikörper binden an körpereigenes Gewebe. Eine Verbindung zwischen Autoimmunität und Malaria ist bekannt: Viele vorherige Studien wiesen Autoantikörper in Malariapatient:innen nach. Gemein haben diese Studien, dass die Autoantikörper erst nach der Malariainfektion gemessen wurden.

„Es war schon lange bekannt, dass die Malariaerkrankung die Bildung von Autoantikörpern auslöst“, sagt Dr. Christine Hopp, Autorin der Studie und Leiterin einer Laborgruppe am BNITM. „Wir wollten testen, ob Autoantikörper, die vor einer Malariaerkrankung im Menschen nachweisbar sind, vor einer fiebrigen Infektion mit dem Malariaparasiten schützen.“
Hopp hat die Studie während ihrer Post-Doc-Phase am National Institute of Allergy and Infectious Diseases in den USA begonnen. Kolleg:innen vom Malaria Research and Training Center in Bamako, Mali, führten die Kohortenstudie vor Ort in Mali durch.
Die Forschenden wählten das Design einer sogenannten beobachtenden Längsschnittstudie: Sie bestimmten die Menge an Autoantikörpern von 602 gesunden Kindern und Erwachsenen in Mali vor der Malariasaison und beobachteten während der nächsten Monate, wer von diesen Proband:innen an Malaria erkrankte. Das Ergebnis: Personen, die viele Autoantikörper besaßen, hatten ein 40 % geringeres Risiko, an einer fiebrigen Malariainfektion zu erkranken. Mit statistischen Methoden kontrollierte das Forscherteam, dass nicht andere Faktoren wie das Alter das Ergebnis verzerrten. „Es sind die Autoantikörper, die mit dem Schutz vor einer fiebrigen Malariainfektion zusammenhängen“, schließt Hopp.

Autoantikörper hemmen Wachstum des Malariaparasiten und binden an Proteine, die wichtig für das Eindringen in rote Blutkörperchen sind
Hopp und ihre Kooperationspartner:innen führten auch Versuche mit Parasitenkulturen durch. Damit untersuchten sie den Mechanismus, wie Autoantikörper vor einer Infektion mit dem Malariaparasiten Plasmodium falciparum schützen können. Sie kultivierten rote Blutzellen mit dem Parasiten. Dieser dringt in die Blutzellen ein, reift dort, vermehrt sich, die Blutzellen platzen und die neu entstandenen Parasiten befallen weitere rote Blutzellen. Gaben die Wissenschaftler:innen Autoantikörper hinzu, wuchsen die Parasiten weniger. Doch warum? Die Forschenden zeigten, dass die Autoantikörper an die Parasiten in den infizierten Blutzellen binden. Um noch genauer zu bestimmen, wo die Autoantikörper an den Parasiten binden, haben sie Bindungsstudien durchgeführt. Die Autoantikörper banden an einige Proteine des Parasiten, die für das Eindringen in die Blutzelle wichtig sind.
Entscheidend für die Zellkulturversuche und die Bindungsstudien war, dass Hopp und ihre Kolleg:innen ein Verfahren entwickelt haben, mit dem sie die Autoantikörper von den übrigen Antikörpern aus den Blutplasmaproben der Proband:innen isolieren konnten.

Malaria übt selektiven Druck auf menschliche Gene aus
„Das Spannende an der Studie ist, dass sie uns Einblick in die Koevolution von Mensch und Malaria gibt,“ sagt Hopp. Unser Immunsystem steht vor folgender schwieriger Aufgabe: Auf der einen Seite sollte es Krankheitserreger als fremde Strukturen erkennen, auf der anderen Seite körpereigene Gewebe und Moleküle als körpereigene Strukturen. Wenn diese Unterscheidung gelingt, erfolgt eine Immunantwort nur gegen fremde Strukturen wie Krankheitserreger. Wie können Krankheitserreger der Immunantwort entgehen? Ein Mechanismus von Pathogenen dafür ist, den körpereigenen Strukturen so zu ähneln, dass der Körper sie nicht als fremd erkennt. Dieser Vorgang wird als molekulare Mimikry bezeichnet. Es scheint wahrscheinlich, dass der Malariaparasit sich im Lauf der langen Koevolution mit uns Menschen zunehmend den körpereigenen Strukturen annäherte. Als Gegenevolution hat sich unser Immunsystem angepasst: Es lässt mehr Autoimmunität zu, da es so eine bessere Immunantwort gegen den Parasiten geben kann.
US-Amerikaner mit afrikanischer Abstammung sind anfälliger gegenüber Autoimmunerkrankungen als Personen mit europäischer Abstammung. „Unsere neuen Daten legen nahe, dass diese höhere Anfälligkeit für Autoimmunerkrankungen möglicherweise vor langer Zeit in Afrika entstanden ist, da bei einer Neigung zur Autoimmunität ein Überlebensvorteil gegenüber Malaria besteht. Unsere Ergebnisse deuten darauf hin, dass Malaria ein starker Antrieb für die Entstehung von Autoimmunität gewesen sein könnte,“ erklärt Hopp.
Originalpublikation
Institutionen der Kooperationspartner:innen
- National Institute of Allergy and Infectious Disease (NIAID), National Institutes of Health (NIH), Rockville, MD, USA
- Yale School of Public Health, Department of Epidemiology of Microbial Diseases, New Haven, CT, USA
- Division of Malaria Research, Proteo-Science Center, Ehime University, Matsuyama, Japan
- Malaria Research and Training Centre, Department of Epidemiology of Parasitic Diseases, International Center of Excellence in Research, University of Sciences, Technique and Technology of Bamako, Mali
- Department of Immunology and Internal Medicine, University of Texas Southwestern Medical Center, Dallas, TX, USA
- Genecopoeia Inc, Rockville, MD, USA
- Centre for Malaria Elimination, Institute of Tropical Medicine, Mount Kenya University, Thika, Kenya
- Department of Medicine, Division of Rheumatology, Lowance Center for Human Immunology and Emory Autoimmunity Center of Excellence, Emory University, Atlanta, GA, USA
- Division of Cell-Free Sciences, Proteo-Science Center, Ehime University, Matsuyama, Japan
Funding
Ansprechperson
Dr. Christine Hopp
Nachwuchsgruppenleiterin
Telefon : +49 40 285380-861
E-Mail : christine.hopp@bnitm.de
Dr. Anna Hein
Presse- & Öffentlichkeitsarbeit
Telefon : +49 40 285380-269
E-Mail : presse@bnitm.de
Weiterführende Informationen